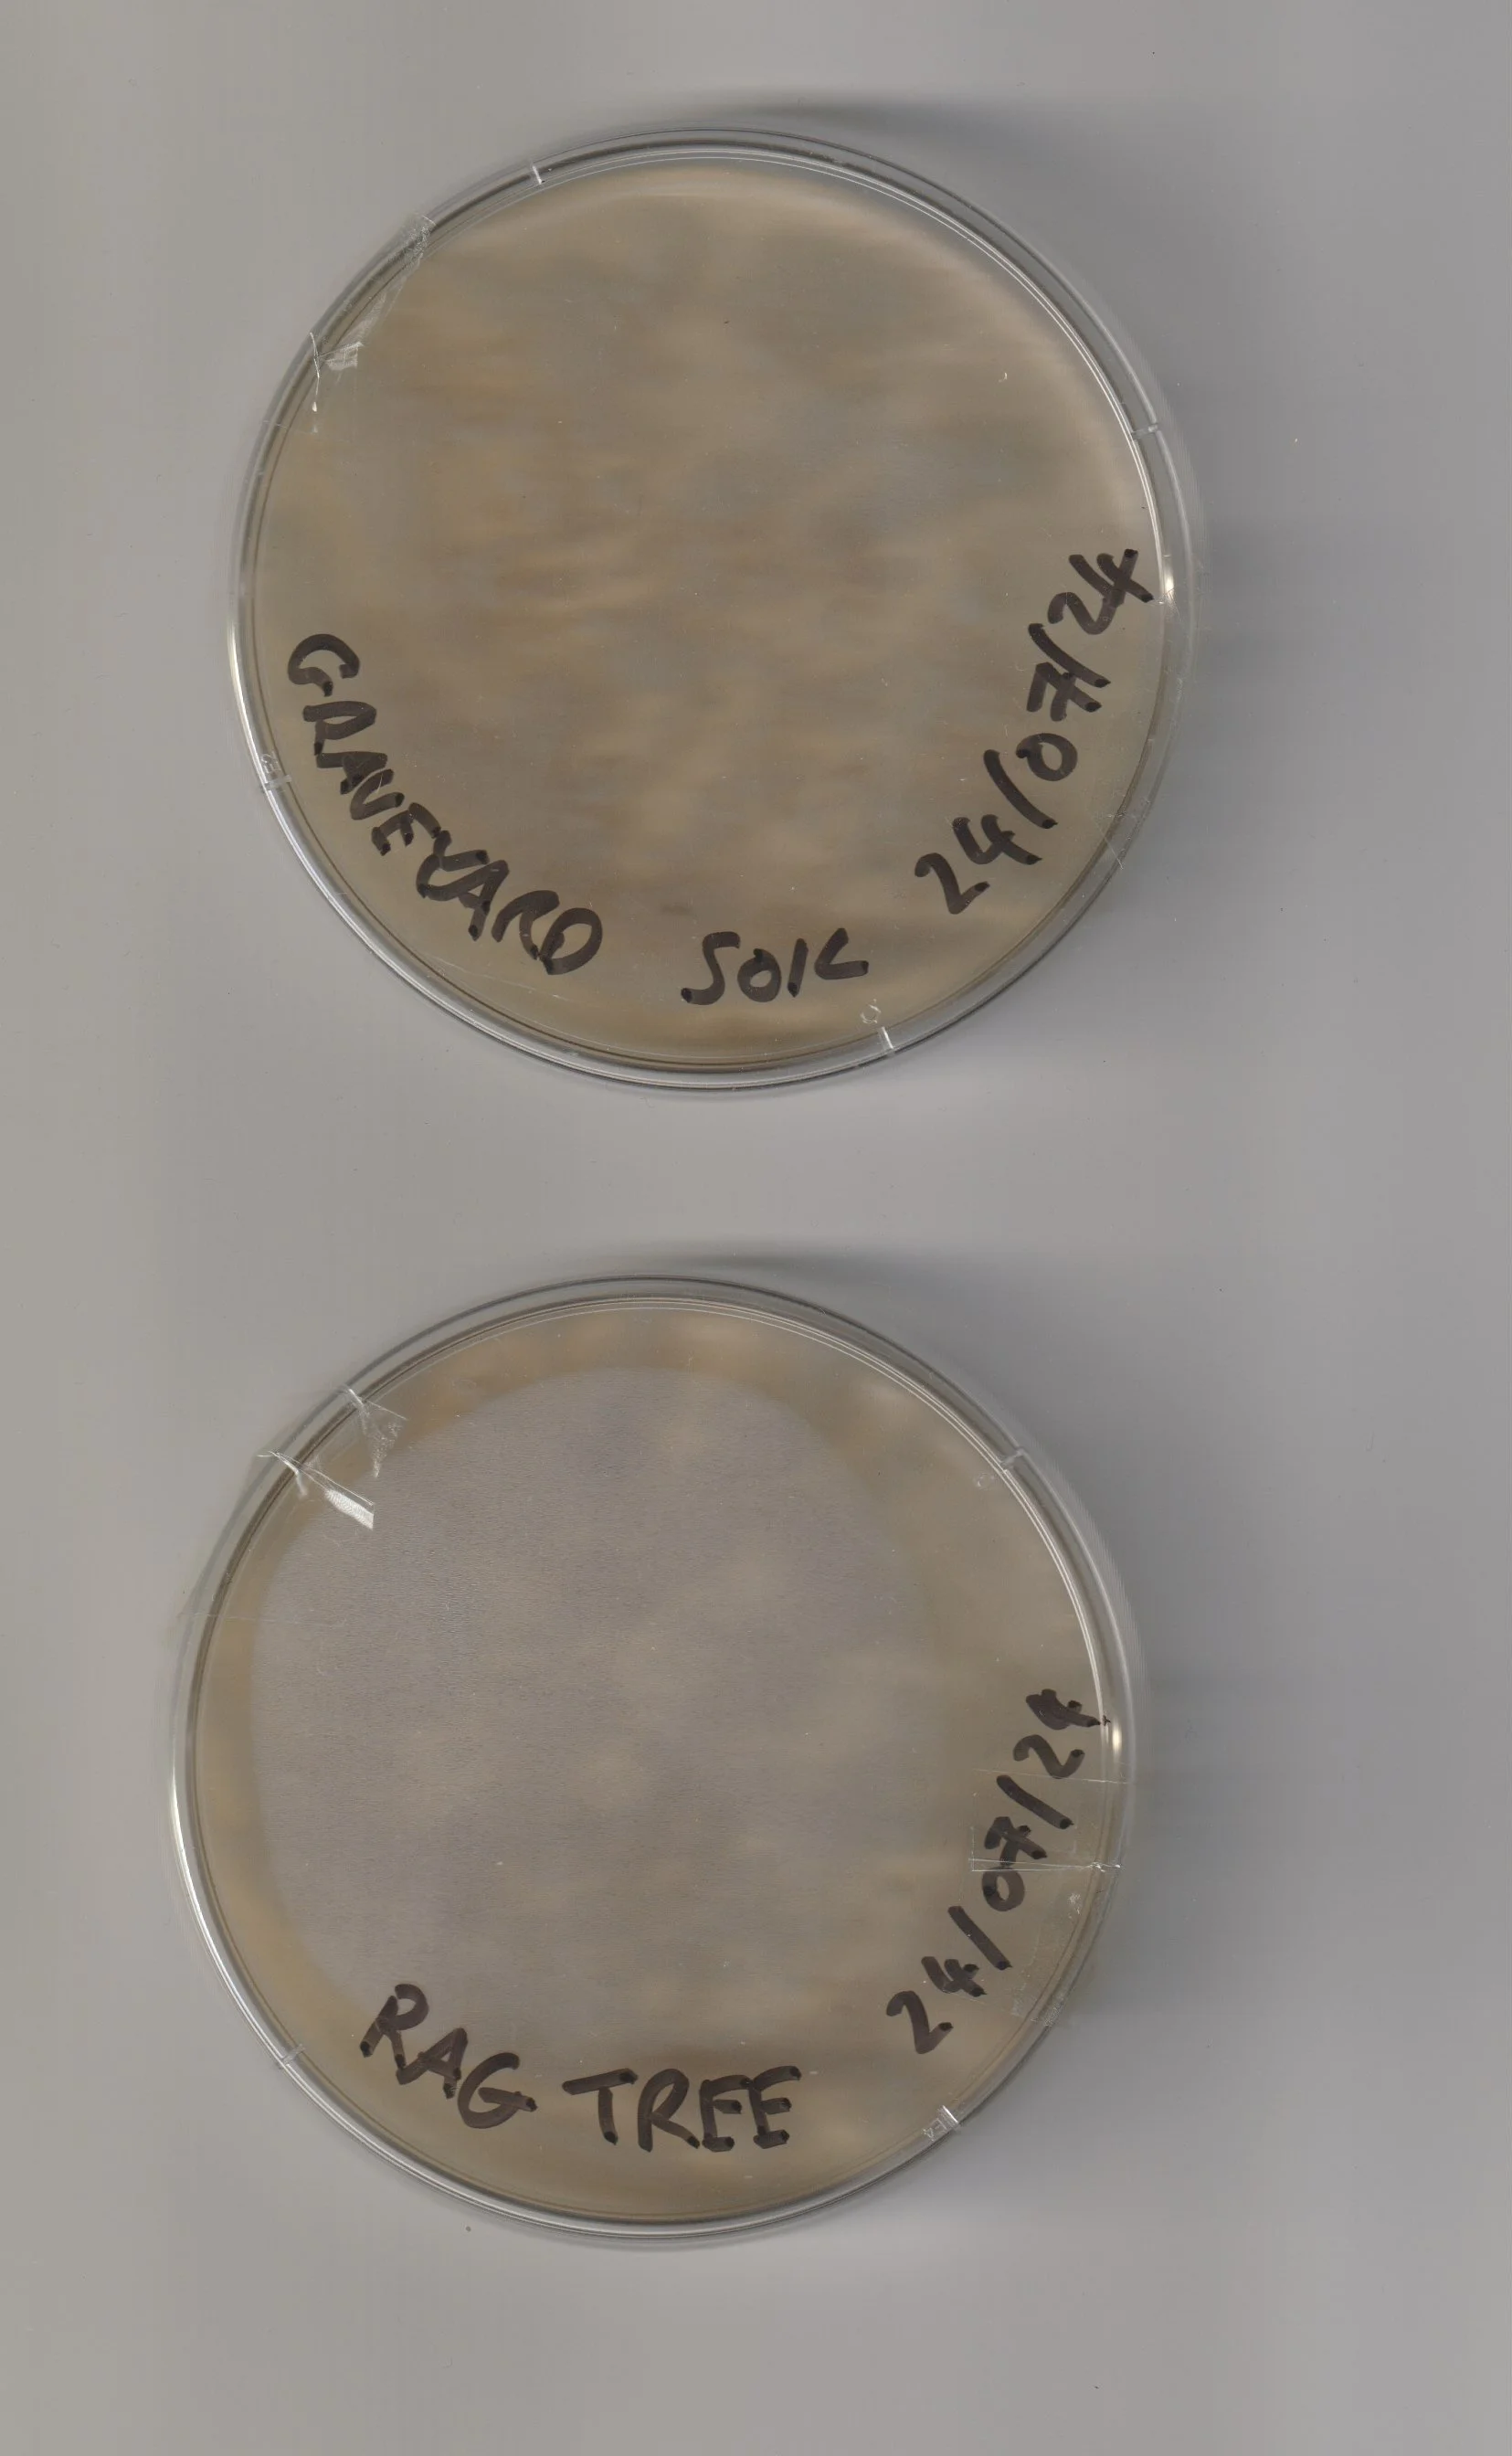
Petri dishes.jpeg

2025/2026



































































































Looking back on 2025, it’s been another busy year; expanding my arts practice into the darkroom supported by Louth Arts office, studying for a post grad with NCAD, exhibitions, facilitating workshops and demos with Creative Spark Print Studio, the Blooming Minds Club and AAEX Teen club.
Exhibitions included Oneiric (Bó Studios group show), Exchange (An AAEX group exhibition) culture night at Bó Studios, finishing up in November with a solo show, It Matters, in Dundalk and graduate show, Structures of Presence, in Dublin.
2026 is shaping up to be just as busy with a residency with the Bristol Folkhouse Darkroom supported by Cavan Arts Office kicking off the year. I’ll be facilitating sustainable photography workshops with the Photo Museum Ireland in the spring and I’ll have an exhibition in the Kiosk, Drogheda in June.
Into the darkroom
Thanks to a bursary from Louth Arts office I was able to free up time to undergo darkroom training with Peter at Monochrome Meath, Chloë at the Bristol Folkhouse Darkroom, Hannah at the Sustainable Darkroom and join the new Creative Spark darkroom, to practice all I had learned before providing workshops and demos to fellow artists and photographers.
Digital Making with NCAD
I was very fortunate to get a place on the inaugural one year, part-time post-grad professional diploma in digital making delivered by NCAD (National College of Art and Design) through Enterprise Fab Lab in Dundalk. There were lots of highlights with the different modules; I loved discovering the philosophy of Donna J Haraway and Yuk Hui. Collaborating with Dr Gerry Quinn on the healing site at Brigid’s Well in Faughart was also a highlight. Fellow students and tutors were amazing and we had great craic invigilating our graduate exhibition, Structures of Presence, during the Beta Festival in Dublin.
The Sustainable Darkroom
Savannah Dodd and Hannah Fletcher from the Sustainable Darkroom delivered a brilliant course over Zoom focused on ethical and ecological photography in 2925. Along with practical homework which led me to make chlorophyll prints, I learned about site specific research which led me to the Old Graveyard at Faughart outside Dundalk. My exhibition at the end of the year, It Matters, was inspired by that research work and the words (discovered on my digital making course) of Donna J Haraway in her book, Staying With the Trouble;
“It matters what matters we use to think other matters with; it matters what stories we tell to tell other stories with; it matters what knots knot knots, what thoughts think thoughts, what descriptions describe descriptions, what ties tie ties. It matters what stories make worlds, what worlds make stories.”